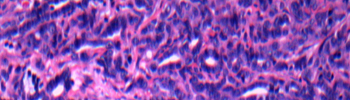
Modeling cancer_tile.jpg

Research Areas
Research in MCCB encompasses a wide range of areas in molecular and cellular biology including cell proliferation, differentiation and death; regulation of gene expression; genome editing; developmental biology; systems biology; metabolism; infectious diseases; and aging. We use variety of experimental systems and model organisms, such as yeast, flies, worms, zebrafish and mice.
In addition, MCCB is the nexus of basic cancer research at UMass Chan. Our faculty study multiple aspects of cancer biology ranging from the study of basic cancer molecular and cell biology to the development of cell-based and animal models for studying cancer initiation, progression and metastasis, to the discovery of novel therapeutic targets for the treatment of cancer. As the only cancer-focused basic research department at UMass Chan, MCCB has actively sought to consolidate cancer research activities within the department and therefore has an extensive network of secondary appointments with faculty who have cancer-related research interests. Our department has strong ties with the UMass Cancer Center, with many MCCB faculty serving as program leaders and/or members.
The diversity in research interests and expertise enables individual faculty to rapidly move into new research areas and learn new experimental methods. MCCB has been highly successful in recruiting new faculty who are up-and-coming leaders in emerging fields (such as cancer metabolism and immunotherapy) and new technologies (such as single-cell genomics and advanced mouse modeling approaches), infusing the department with innovative ideas and methodologies that help keep our research program cutting-edge.

Regulation of Gene Expression
When and where genes are turned on and off must be carefully coordinated. Not surprisingly, this process often goes awry during cancer initiation and progression. Learn how MCCB researchers study the control of gene expression.

Genome Editing
New technologies permit precise manipulation of DNA sequence within a cell or organism. See how MCCB researchers are developing and applying this new technology to model and treat disease.

Cell Life & Death
Cells proliferate, differentiation, and die during normal tissue construction and maintenance. During cancer these processes are preturbed, leading to uncontrolled growth. See how MCCB researchers study these basic cellular processes in both normal and disease settings.
Modeling Cancer
The development of novel therapeutics relies on appropriate animal and cell-based models to study factors that contribute to cancer initiation and progression. See how MCCB researchers take advantage of unique models, from humanized mice to knockout zebrafish, to study cancer and related diseases.

Cancer Drug Discovery
Learn how MCCB researchers are identifying new drugs and discovering novel therapeutic targets for the treatment of cancer and other diseases.

Tumor Growth & Metastasis
Similar to normal tissue, tumors require a blood supply and interaction with surrounding cells to grow. However, unlike normal tissue, tumor cells often enter into the bloodstream where they can metastasize to distant sites. Learn how MCCB researchers investigate these important steps in cancer progression.

Metabolism & Disease
Cells require nutrients to generate the basic building blocks of DNA, RNA, proteins and membranes. These biochemical processes are often affected in cancer and age-related diseases. Learn how MCCB researchers are studying the important links between metabolism and disease.

Infection & Disease
Viral, bacterial and fungal infections are a constant public health threat and can contribute to the pathogenesis of cancer and related diseases. See how MCCB researchers study various pathogens in an effort to develop new therapies for their eradication.